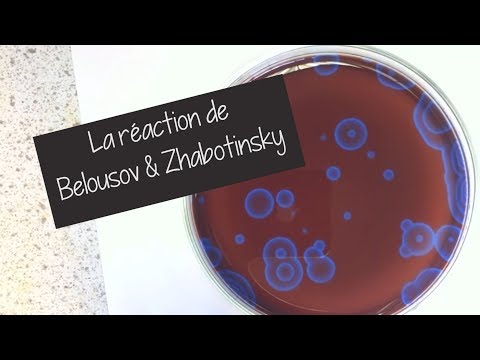

- Orijinal sürüm
- Önceki bölüm S01E21 - I.6. ÉLECTROPHILIE
- Sayı S01E22
-
Dış bağlantılar
YouTube dosyası
-
Son güncelleme
23 avril 2026 - 14:15
11 veritabanında
La réaction de Belousov et Zhabotinsky
Nous étudions une réaction chimique oscillante très connue : la réaction de Belousov et Zhabotinsky.
Le travail présenté ici a été réalisé par Elodie et Vincent, avec l'aide de Monsieur Micheau.
Je leur adresse tous mes remerciements !
Organisation :
- Introduction
I. Mise en oeuvre expérimentale (2:20)
II. Modélisation
1. Mécanisme simplifié (6:40)
2. Simulation numérique (10:15)
3. Confrontation expérience / simulation numérique (12:50)
- Digression (14:25)
- Conclusion (15:50)
Site internet : blablareau-chimie.fr
Réseaux sociaux :
- Facebook : https://www.facebook.com/BlablareauAu...
- Instagram : blablareau_au_labo
- Twitter : @Blablareau
Soutenir la création de vidéos :
- Tipeee : https://en.tipeee.com/blablareau-au-labo
- TipLink : https://www.utip.io/blablareauaulabo
PS : J'ai eu des problèmes de son avec cette vidéo ...